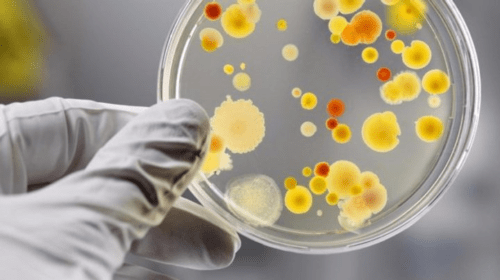

Допит свідків та вивчення доказів завершилися лише за один день – 18 липня. Сьогодні в суді також пройшли дебати сторін
Читати даліДень: 19.07.2024
Вже палає в степах українського Донбасу: ЗСУ збили російський штурмовик Су-25
Сьогодні українські військові збили російський штурмовий літак Су-25. Він вже палає в степах українського Донбасу.
Про це повідомляє редакція сайту 056 з посиланням на ОСУВ "Хортиця".
Російський літак збили на Покровському напрямку бійці 110-ої окремої механізованої бригади імені Марка Безручка. Він намагався обстрілювати позиції підрозділів Сил оборони.
Читати даліЗбій у роботі IT-систем: директор CrowdStrike повідомив, що проблему ідентифікували
«Проблему виявлено, ізольовано та розпочато її виправлення», повідомив Курц
Читати даліМобілізація по-новому: чи продовжать працівники ТЦК видавати повістки на вулицях
Останнім часом у суспільстві все більше обговорюється питання щодо змін у процедурі видачі повісток військовозобов'язаним. Зокрема, обговорюється можливість припинення видачі їх на вулицях та в громадських місцях. Нардеп Михайло Цимбалюк висловив свої думки з цього приводу, підкреслюючи важливість змін у процесі призову.
Читати даліЯк швидко та просто розрізати бісквіт без ножа: лайфхак, про який ви точно не знали
Бісквіт — одна з найулюбленіших основ для тортів, яка славиться своєю ніжною текстурою та пишністю. Проте, навіть ідеально випечений бісквіт може бути зіпсований нерівним розрізом. Ця проблема знайома багатьом домогосподаркам та кондитерам. Однак, сучасні технології та соціальні мережі відкривають перед нами нові можливості.
Читати даліВ Україні мінімум 6 млн чоловіків підпадають під штрафи за те, що не оновили свої військово-облікові дані: подробиці
В Україні щонайменше 6 мільйонів військовозобов’язаних чоловіків не встигли оновити свої військово-облікові дані до 16 липня. Таким чином, всі вони підпадають під штрафи.
Читати даліНа Дніпропетровщині родина заразилася сальмонелою: через який продукт та де його купили
Літня спека сприяє швидшому розмноженню збудників кишкових інфекцій. Так, минулого тижня на Дніпропетровщині було виявлено спалах гострої кишкової інфекції. У Кривому Розі. Постраждала родина з 4 осіб (3 дітей, 1 доросла) через вживання у їжу курячих яєць, придбаних на стихійній торгівлі, забруднених сальмонелою.
Читати даліВнаслідок ДТП на Амурському мосту у Дніпрі утворився кілометровий затор
Вчора ввечері, 18 липня, близько 17:21, у Дніпрі сталася ДТП на в'їзді на Амурський міст зі сторони лівого берега. Там зіткнулися «ГАЗель» та Citroen. Через ДТП утворився кілометровий затор по переправі у напрямку лівого берега.
Читати даліОдних взагалі не відключали, а інших заживлювали пізніше запланованого: які порушення ГПВ на Дніпропетровщині
Держенергонагляд здійснив перевірки застосування операторами системи розподілу (обленерго) графіків погодинних відключень та справедливого розподілу електроенергії в областях. На першому етапі відбулися перевірки у Дніпропетровській, Вінницькій, Житомирській, Івано-Франківській, Кіровоградській та Одеській областях.
Про це повідомляє редакція сайту 056 з посиланням на Державну інспекцію енергетичного нагляду України.
Читати даліДерженергонагляд виявив численні порушення при відключеннях в регіонах
Держенергонагляд виявив численні порушення під час перевірок застосування операторами системи розподілу (обленерго) графіків погодинних відключень (ГПВ) та справедливого розподілу електроенергії в областях.
Як йдеться в повідомленні Держенергонагляду, наразі вже відбулися перевірки у Вінницькій, Дніпропетровській, Житомирській, Івано-Франківській, Кіровоградській та Одеській областях.
У ході перевірок встановлено, що в усіх областях не забезпечено максимально можливий рівномірний розподіл обсягів зниження споживання між споживачами.